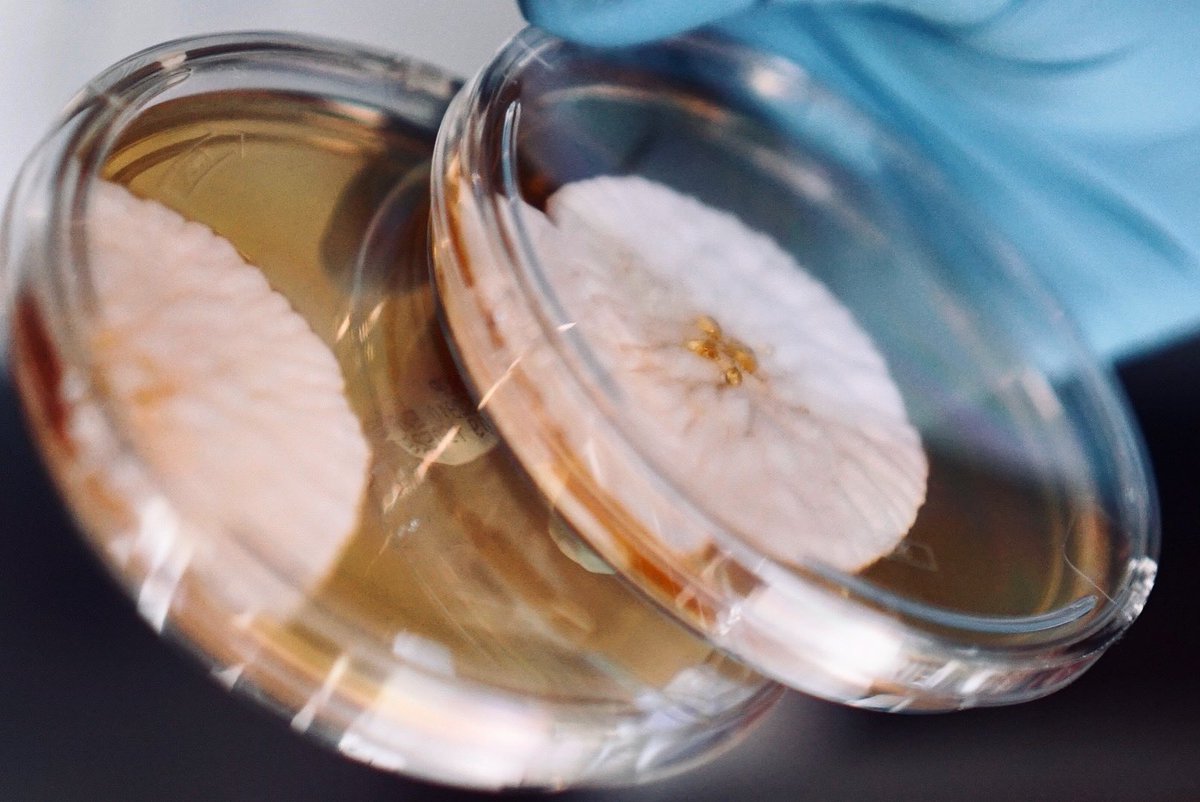
hopebiosciences's tweet image. Think microbes are flourishing in your samples? Send them over to us to nip the contamination in the bud! 🌼 #QualityControl #microbiology #MicrobialDetection
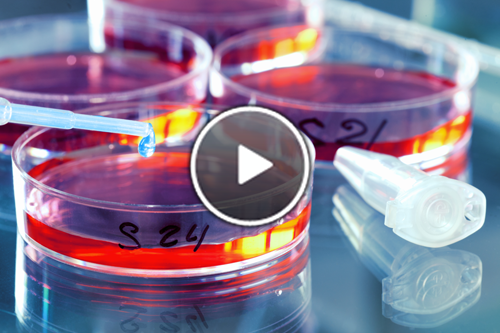
SelectScience's tweet image. New videos: #microbialdetection, improving your #cellculture and verifying #contamination bit.ly/1NbKhtd

#microbialdetection search results
Think microbes are flourishing in your samples? Send them over to us to nip the contamination in the bud! 🌼 #QualityControl #microbiology #MicrobialDetection

Detect bacteria in minutes—no lab needed. M/D 1.0 Rapid Microbial Detection Test ✔️15-min results ✔️<100 CFU/ml sensitivity ✔️Works anywhere Learn more: bio-organic.com/microbial-dete… #WaterTesting #MicrobialDetection #Innovation #CleanWater #PublicHealth

Proper and accurate monitoring of pharma water systems is imperative to deliver the highest quality products. Download this eBook and read articles written to help you meet the demands of ever-stricter water testing regulations. #TOC #MicrobialDetection okt.to/kWVbps

New videos: #microbialdetection, improving your #cellculture and verifying #contamination bit.ly/1NbKhtd

Fison Bacterial Air Sampler FM-BAS-A100 is a high performance device designed for monitoring and analysing airborne microbial contamination in various environments. Mail: [email protected] Website: fison.com/bacterial-air-… #fison #AirQualityMonitoring #MicrobialDetection

Going global! 🌍 #Fuyang Tailin Bioengineering's #medicalproducts reach over 40 countries, leading in smart, rapid #microbialdetection. Know a medtech enthusiast? Tag them to share this! #GlobalHealth



Don’t forget! As you prep for year-end, Huankai Month is still here—celebrating 31 years of excellence! 🎉 Get 5% in FREE products with every order through November. Stock up now and step into the new year ready! #HuankaiAnniversary #HuankaiMonth #MicrobialDetection #FoodSafety…

Watch to learn how EZ-Fit® filtration units are smartly designed to make #bioburden testing faster and easier. Explore the Millipore® portfolio for #MicrobialDetection and #Monitoring: sigmaaldrich.com/portfolio/mill… #microbiology #TeamMerck bit.ly/3tybaAz

Revolutionize Compliance with #Tailin's Online Microbial Monitoring System MD500! Facing stricter global regulations when monitoring pharmaceutical water system? Tailin's MD500 is your game-changer! #MicrobialDetection #Pharmaceuticals #Watertest

News: Hygiena launches all-in-one Listeria, L. monocytogenes detection method bit.ly/Hyg0204 #foodsafety #foodtesting #microbialdetection #microbiology

Anne-Grit Klees explains how our MAS-100 NT® #portableairmonitors consistently provide accurate results. Explore the Millipore® portfolio for #MicrobialDetection and #Monitoring sigmaaldrich.com/portfolio/mill… #MilliporeMinds #TeamMerck bit.ly/3bxKklU

Are you developing microbial media for a novel application? Whether you are developing an assay in liquid or solid media, in aerobic or anaerobic conditions, the review will guide you through the options. #microbialdetection #microbialmedia bit.ly/3beLVur

Sam Santiago explains how MC-Media Pad® tests provide fast and accurate #microbialtesting results without sacrificing quality. Explore our portfolio for #MicrobialDetection and #Monitoring:... #TeamMerck bit.ly/3ng1wyZ

Do you want to reduce filtration costs and improve process safety? Ensure microbial stability and good shelf life – Protect your product. Protect your brand. Our solution designed for breweries. Shop now! bit.ly/3iETnBs #drinktec #beerspoilage #microbialdetection

Discover the future of Automatic Microbial Detection Tools! The market is set to grow from $298M in 2023 to $457.1M by 2030. Dive into the details here: reports.valuates.com/market-reports… #MicrobialDetection #GlobalMarket #HealthcareInnovation

Great news! @rapidmicrobio just raised $120m to accelerate the global expansion of its automated microbial detection platform: lnkd.in/g8C68Fd #XerayaCapital #pharmaceuticalmanufacturing #microbialdetection

Join TWT's own Dr. Christopher Impellitteri and Anna Impellitteri as well as our friends at @QIAGEN for the American Society of Microbiology Conference on June 16 🔬🦠 Learn more: asm.org/Events/ASM-Mic… #research #PCR #microbialdetection #ASMMicrobe2024
Rapid Micro Biosystems is the leading provider of automated, growth-based, rapid microbial detection technology for the healthcare product manufacturing sector #rapidmicro #microbialdetection #growthdirect #xerayacapital xeraya.com/#!/rapidmicro-…

Rapid Micro Biosystem's Growth Direct is the first and only growth-based system to fully automate traditional microbial testing - detects contamination more quickly #rapidmicro #microbialdetection #growthdirect #xerayacapital xeraya.com/#!/rapidmicro-…

Rapid Micro Biosystem's Growth Direct aims at delivering compelling economic benefits to manufacturers while improving their quality control operations and reducing operational risks #rapidmicro #microbialdetection #growthdirect #xerayacapital xeraya.com/#!/rapidmicro-…

Detect bacteria in minutes—no lab needed. M/D 1.0 Rapid Microbial Detection Test ✔️15-min results ✔️<100 CFU/ml sensitivity ✔️Works anywhere Learn more: bio-organic.com/microbial-dete… #WaterTesting #MicrobialDetection #Innovation #CleanWater #PublicHealth

Going global! 🌍 #Fuyang Tailin Bioengineering's #medicalproducts reach over 40 countries, leading in smart, rapid #microbialdetection. Know a medtech enthusiast? Tag them to share this! #GlobalHealth



Revolutionize Compliance with #Tailin's Online Microbial Monitoring System MD500! Facing stricter global regulations when monitoring pharmaceutical water system? Tailin's MD500 is your game-changer! #MicrobialDetection #Pharmaceuticals #Watertest

Discover the future of Automatic Microbial Detection Tools! The market is set to grow from $298M in 2023 to $457.1M by 2030. Dive into the details here: reports.valuates.com/market-reports… #MicrobialDetection #GlobalMarket #HealthcareInnovation

Don’t forget! As you prep for year-end, Huankai Month is still here—celebrating 31 years of excellence! 🎉 Get 5% in FREE products with every order through November. Stock up now and step into the new year ready! #HuankaiAnniversary #HuankaiMonth #MicrobialDetection #FoodSafety…

Join Us Tomorrow for a Live Webinar - How to Achieve Growth Based Microbial Contamination Detection in Less than 24 Hours 🌐 Register Here: workcast.com/register?cpak=… 🗓️ Date: September 19, 2024 | 🕖 Time: 7AM Pacific See you there! 👋 #PharmaWebinar #MicrobialDetection #RMM

Our Milliflex Oasis® bioburden testing system is designed with your needs in mind. Frederic Amstoutz, Global Product Manager, explains how it saves you time and reduces the risk of errors. #microbialmonitoring #microbialdetection #TeamMilliporeSigma bit.ly/3SawGrr

TaqPath BactoPure Microbial Detection Master Mix by @thermofisher is optimized for rapid low-level microbial detection even in the presence of PCR inhibitors. #thermofisher #mastermix #microbialdetection #igb igbiosystems.com/taqpath-bactop…
Join TWT's own Dr. Christopher Impellitteri and Anna Impellitteri as well as our friends at @QIAGEN for the American Society of Microbiology Conference on June 16 🔬🦠 Learn more: asm.org/Events/ASM-Mic… #research #PCR #microbialdetection #ASMMicrobe2024
Lower detection limits mean better sterility testing. The future of microbial detection is here with Symcel's calScreener™. See how #MicrobialDetection #Biocalorimetry #Innovation The calScreener in Rapid Sterility Testing for Cell and Gene Therapy eu1.hubs.ly/H06C_GB0
Stay Ahead of Engine Troubles with Fresh Oil Insight - It's Your Engine's Lifeline! Discover the power of Qualitas Material Testing, ensuring your engine's vitality. qualitasme.com . . #qualitas #qualitasmaterialtesting #microbialdetection #enginecare #qualitasinsight
Surface safety assured: Qualitas Lab in UAE delivers accurate detection of microbial and chemical threats. Our commitment to precision safeguards your environment.🦠🧪 Visit us at - qualitasme.com . . #qualitas #qualitasmaterialtesting #microbialdetection #labtesting

Lower detection limits mean better sterility testing. The future of microbial detection is here with Symcel's calScreener™. Click and see how The calScreener in Rapid Sterility Testing for Cell and Gene Therapy #MicrobialDetection #Symcel eu1.hubs.ly/H04LF4K0
Our Milliflex Oasis® bioburden testing system was designed with your needs in mind. Frederic Amstoutz, Global Product Manager, explains how it saves you time and reduces the risk of errors. #pharma #microbialmonitoring #microbialdetection #TeamMerck bit.ly/3AdsZb4
Our Milliflex Oasis® bioburden testing system is designed for your needs. Frederic Amstoutz, Global Product Manager, explains how it saves you time and reduces the risk of errors. #pharma #microbialmonitoring #microbialdetection #TeamMilliporeSigma bit.ly/3ootCvV
Do you want to reduce filtration costs and improve process safety? Ensure microbial stability and good shelf life – Protect your product. Protect your brand. Our solution designed for breweries. Shop now! bit.ly/3iETnBs #drinktec #beerspoilage #microbialdetection

Proper and accurate monitoring of pharma water systems is imperative to deliver the highest quality products. Download this eBook and read articles written to help you meet the demands of ever-stricter water testing regulations. #TOC #MicrobialDetection okt.to/kWVbps

Free bonus trial alert! 🚨 For a limited time, get the Applied Biosystems™ TaqPath™ BactoPure™ Microbial Detection Master Mix for free👨🔬. Optimized for rapid low-level #microbialdetection for use in a variety of targets in complex samples🥼. bit.ly/3SlcktJ

Lyssa Sakaley, Senior Global Product Manager, explains how the Assurance® GDS system for #pathogendetection can streamline your work.Explore the Millipore® portfolio for #MicrobialDetection and #Monitoring:... #TeamMerck bit.ly/3C1gcKZ
Environmental monitoring: a critical and challenging requirement Read about bioMérieux’s new system, 3P® ENTERPRISE – an end-to-end solution that fully digitalises and automates the EM process: okt.to/RA2ng0 #EnvironmentalMonitoring #DataIntegrity #MicrobialDetection
Detect bacteria in minutes—no lab needed. M/D 1.0 Rapid Microbial Detection Test ✔️15-min results ✔️<100 CFU/ml sensitivity ✔️Works anywhere Learn more: bio-organic.com/microbial-dete… #WaterTesting #MicrobialDetection #Innovation #CleanWater #PublicHealth

GIVEAWAY ALERT! Free Environmental Monitoring Kit Today! Promotion expires July 1, 2020 #PeelPlate #FoodSafety #MicrobialDetection #NothingWorksLikeACharm

Fison Bacterial Air Sampler FM-BAS-A100 is a high performance device designed for monitoring and analysing airborne microbial contamination in various environments. Mail: [email protected] Website: fison.com/bacterial-air-… #fison #AirQualityMonitoring #MicrobialDetection

Think microbes are flourishing in your samples? Send them over to us to nip the contamination in the bud! 🌼 #QualityControl #microbiology #MicrobialDetection
Watch to learn how EZ-Fit® filtration units are smartly designed to make #bioburden testing faster and easier. Explore the Millipore® portfolio for #MicrobialDetection and #Monitoring: sigmaaldrich.com/portfolio/mill… #microbiology #TeamMerck bit.ly/3tybaAz

Great news! @rapidmicrobio just raised $120m to accelerate the global expansion of its automated microbial detection platform: lnkd.in/g8C68Fd #XerayaCapital #pharmaceuticalmanufacturing #microbialdetection

New videos: #microbialdetection, improving your #cellculture and verifying #contamination bit.ly/1NbKhtd
Going global! 🌍 #Fuyang Tailin Bioengineering's #medicalproducts reach over 40 countries, leading in smart, rapid #microbialdetection. Know a medtech enthusiast? Tag them to share this! #GlobalHealth



How Luxembourg detects microbes in its water supply before they pose a health risk: tinyurl.com/33z57rnr For More Details Visit Our Website IDAMR 2026 :infectiousdiseasesconclave.com #WaterSafety #MicrobialDetection #PublicHealth #WaterQuality #SafeWater #Innovation #HealthSecurity

Proper and accurate monitoring of pharma water systems is imperative to deliver the highest quality products. Download this eBook and read articles written to help you meet the demands of ever-stricter water testing regulations. #TOC #MicrobialDetection okt.to/kWVbps

Anne-Grit Klees explains how our MAS-100 NT® #portableairmonitors consistently provide accurate results. Explore the Millipore® portfolio for #MicrobialDetection and #Monitoring sigmaaldrich.com/portfolio/mill… #MilliporeMinds #TeamMerck bit.ly/3bxKklU

Sam Santiago explains how MC-Media Pad® tests provide fast and accurate #microbialtesting results without sacrificing quality. Explore our portfolio for #MicrobialDetection and #Monitoring:... #TeamMerck bit.ly/3ng1wyZ

News: Hygiena launches all-in-one Listeria, L. monocytogenes detection method bit.ly/Hyg0204 #foodsafety #foodtesting #microbialdetection #microbiology

Rapid Micro Biosystem's Growth Direct is the first and only growth-based system to fully automate traditional microbial testing - detects contamination more quickly #rapidmicro #microbialdetection #growthdirect #xerayacapital xeraya.com/#!/rapidmicro-…

Rapid Micro Biosystems is the leading provider of automated, growth-based, rapid microbial detection technology for the healthcare product manufacturing sector #rapidmicro #microbialdetection #growthdirect #xerayacapital xeraya.com/#!/rapidmicro-…

Rapid Micro Biosystem's Growth Direct aims at delivering compelling economic benefits to manufacturers while improving their quality control operations and reducing operational risks #rapidmicro #microbialdetection #growthdirect #xerayacapital xeraya.com/#!/rapidmicro-…

Discover the future of Automatic Microbial Detection Tools! The market is set to grow from $298M in 2023 to $457.1M by 2030. Dive into the details here: reports.valuates.com/market-reports… #MicrobialDetection #GlobalMarket #HealthcareInnovation

EDQM #Microbiology Symposium 10Oct. alternative & #rapidmethods 4 #microbialdetection of #Yeast #Molds bit.ly/2n9ghGJ

Don’t forget! As you prep for year-end, Huankai Month is still here—celebrating 31 years of excellence! 🎉 Get 5% in FREE products with every order through November. Stock up now and step into the new year ready! #HuankaiAnniversary #HuankaiMonth #MicrobialDetection #FoodSafety…

Join Us Tomorrow for a Live Webinar - How to Achieve Growth Based Microbial Contamination Detection in Less than 24 Hours 🌐 Register Here: workcast.com/register?cpak=… 🗓️ Date: September 19, 2024 | 🕖 Time: 7AM Pacific See you there! 👋 #PharmaWebinar #MicrobialDetection #RMM

Something went wrong.
Something went wrong.
United States Trends
- 1. Thanksgiving 2.41M posts
- 2. Post Malone 4,011 posts
- 3. Lions 98.1K posts
- 4. Packers 69.8K posts
- 5. Dan Campbell 7,767 posts
- 6. #GoPackGo 11.4K posts
- 7. McDuffie 3,252 posts
- 8. Romo 5,620 posts
- 9. Malik Davis 2,015 posts
- 10. #ChiefsKingdom 4,687 posts
- 11. #KCvsDAL 4,318 posts
- 12. Wicks 11.8K posts
- 13. Kenneth Murray N/A
- 14. Jordan Love 18.3K posts
- 15. Micah Parsons 13.5K posts
- 16. Goff 11.7K posts
- 17. #DallasCowboys 3,941 posts
- 18. Kelce 12.9K posts
- 19. Jack White 10.8K posts
- 20. Caleb Wilson 1,754 posts



























